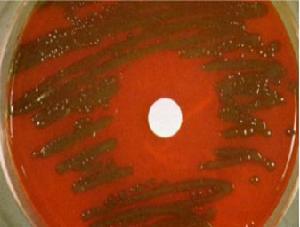
急性化膿性蜂窩織炎性胃炎

流行病學
肺炎雙球菌
肺炎雙球菌本病的致病菌大多為溶血性鏈球菌(70%),其次是肺炎雙球菌、金黃色葡萄球菌、大腸埃希桿菌、變形桿菌,亦可為嗜血桿菌、梭狀芽孢桿菌、銅綠假單胞桿菌等。
細菌可經下列途徑侵入胃壁:
1、由身體其他部位的感染病灶經血液播散至胃,多見於敗血症、產褥熱、皮膚癤腫、骨髓炎、猩紅熱等患者;
2、呼吸道、口腔分泌物中的細菌進入胃腔而感染,急慢性胃炎、胃潰瘍、胃手術、酗酒等造成的胃黏膜損傷,為發病的誘因;
3、細菌自附近的感染灶如腹膜炎、膽囊炎經淋巴管進入胃壁 衰弱、營養不良及脾切除術常為全身性誘因。感染一般先始自黏膜下層,引起黏膜的壞死、脫落,可向外發展累及肌層和漿膜層,並可引起化膿性腹膜炎。
病因
急性化膿性蜂窩織炎性胃炎,與下列因素有關:
1、胃本身患有器質性病變如潰瘍、慢性胃炎等,食入的細菌可直接侵入破潰的胃壁組織造成感染。
2、身體其他部位的感染,如亞急性細菌性心內膜炎、敗血症等病原菌可由血流進入胃壁內,造成感染。
3、腹腔記憶體在感染灶如膽囊炎、闌尾炎等 細菌可經淋巴途逕到達胃壁。在身體抵抗力減弱時,如飲酒、營養不良等 易於發病。
發病機制
 病因酗酒
病因酗酒1、發病部位:化膿性損害以胃遠端1/2為常見,亦可遍及全胃,但很少超過幽門或賁門 病變部位主要在黏膜下層,並向黏膜及漿膜側擴散,有時可出現穿孔。
2、病理改變: 根據病變範圍有瀰漫型和局限型兩種。
(1) 瀰漫型:臨床多見。胃壁暗紅色,呈瀰漫性增厚,擠壓胃壁時可見膿液流出。但很少超過賁門或幽門,嚴重者可出現胃腔擴張、胃壁穿孔等。
(2) 局限型:多在胃竇部形成局限性膿腫。肉眼觀察,可見胃黏膜充血,可有糜爛、潰瘍、壞死及出血,顯微鏡下可見黏膜下層及肌層間質中血管充血,胃壁布滿纖維性網眼結構,其中含有膿液,並有大量白細胞浸潤。
臨床表現
常以急腹症形式發病。突然出現上腹部疼痛、伴發熱、寒戰、噁心、嘔吐等。腹痛可漸進性加重,坐位時疼痛有所緩解 臥位時加重,此為本病具有特異性的症狀。隨著病情的發展 體溫可進一步升高,嘔吐物可由膿性液變為膿血性液 尚可出現腹脹、腹膜炎體徵及黑便,但多無腹瀉 病程後期可出現休克徵象,與細菌毒素造成的感染中毒及失血、失液有關。嚴重病例休克出現較早,預後不良。除早期外常有腹膜炎體徵,腹部較膨隆、壓痛、反跳痛及肌緊張,以上腹部為重。如炎性滲出液較多 可有炎性腹水,表現為移動性濁音陽性,但罕有大量腹水。腸鳴音在早期亢進,以後則漸弱或消失。
併發症
急性腹膜炎和感染性休克是本病常見的併發症。
診斷
 患者
患者本病缺乏特異性的症狀及體徵,輔助檢查亦很少特異性指標,故診斷困難。關鍵的問題是在急腹症時要考慮到化膿性胃炎的可能,再重點考慮以下幾點對診斷或許有所幫助。
1、常有慢性胃部疾患或長期胃部不適。
2、常有不潔飲食史或身體其他部位的感染性疾患。
3、發熱常與腹痛同步,甚至在腹痛出現前即可出現。
4、一般腹膜炎時患者多不喜活動,而本病患者常躁動,坐位時疼痛較輕。
5、嘔吐物多為膿性 以後可為膿血性。
鑑別診斷
 急性胰腺炎
急性胰腺炎常需首先除外以下疾病,再結合上述診斷要點 即可得到正確診斷。
1、潰瘍病穿孔:初起即為突然發生的劇烈刀割樣疼痛,很快波及全腹,發熱較遲出現,腹肌呈木板樣強直,腹膨隆較少出現,肺肝濁音界減小,腹腔內液體量較多,常為消化液。腹透可見膈下游離氣體。
2、急性化膿性膽囊炎或膽管炎:腹痛常波及右肩背部,壓痛及肌緊張常局限於右上腹,常伴有黃疸,有時於腹部可捫及腫大膽囊。B超檢查有重要價值。
3、急性胰腺炎:常有暴飲暴食或酗酒史。腹痛漸進性加重,常累及腰背部,發熱出現較晚。血、尿澱粉酶檢查有特殊價值。
檢查
 檢查
檢查實驗室檢查:
外周血白細胞數升高,多在1×1010/L以上 以中性粒細胞為主,並出現核左移現象。胃液、腹水、血液細菌培養可發現致病菌。
其它輔助檢查:
1、X線腹部平片:顯示胃擴張,胃壁內有氣泡存在。
2、X線鋇餐和胃鏡檢查:一般應列為禁忌,以免引起胃穿孔。回顧性胃鏡檢查資料顯示胃腔狹小,胃黏膜充血、增厚,黏膜表面膿苔附著,可伴有多發性潰瘍。
3、B型超聲檢查:顯示胃壁明顯增厚。
相關檢查:
> 白細胞計數
治療
 抗生素
抗生素治療的成功與否取決於能否早期診斷。
1、非手術治療:通過套用大劑量廣譜抗生素及積極手術可提高存活率。當出現水、電解質及酸鹼平衡紊亂或休克時,應積極糾正,同時加強輸血、補液等一般支持療法,大部分病例經保守治療有望痊癒。
2、手術治療:如保守治療期間腹膜炎未減輕或反而加重 則認為是手術的適應證。手術方式有胃蜂窩織炎引流術及胃部分切除術。在患者病情許可的情況下以後者為宜。腹腔內應常規注入適量抗生素。如病灶切除及腹腔清理較徹底,可不放置引流。經綜合治療後的化膿性胃炎存活率近70%。
3、術後處理:需手術治療的患者病程往往已為中晚期,病情較重,術後應注意以下情況:持續胃腸減壓,保持引流通暢;監測生命體徵,密切注意水、電解質及酸鹼平衡;注意腎功能變化;繼續套用大劑量廣譜抗生素;加強營養支持,條件允許應給予靜脈營養。
預後
本病病死率極高,在抗生素問世以前,病死率高達83%~92%。使用抗生素治療後病死率降至48%,早期足量的抗生素治療可挽救約一半患者的生命。糾正水電解質平衡紊亂、抗休克、支持療法也不應忽視。外科手術病死率為18.2% 明顯低於保守治療,然而對於瀰漫型或並發腹膜炎者,即使手術治療,預後也很差。總之,本病治療成功的關鍵在於早期發現,立即套用足量抗生素,根據病情及早行手術治療。
